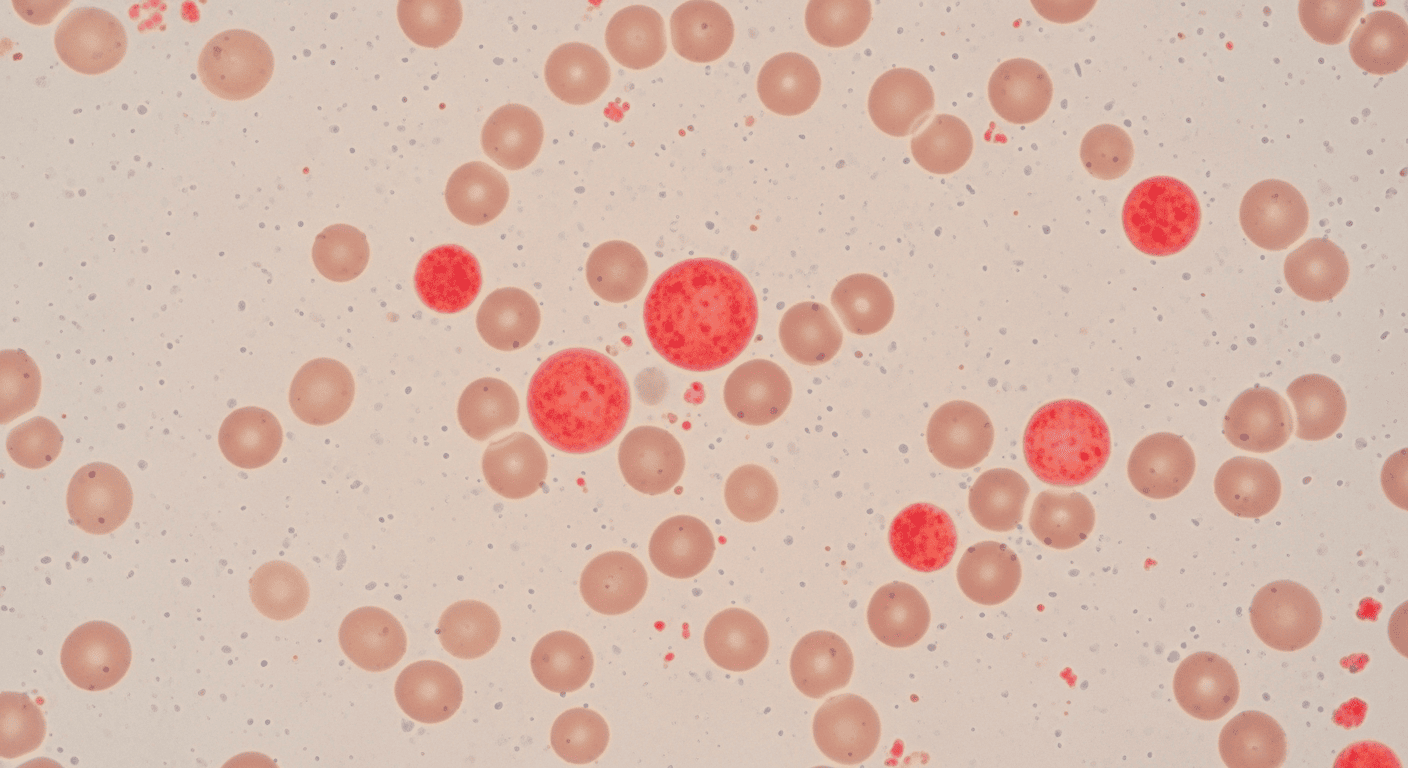
Ширина распределения эритроцитов RDW

Гранулоциты — белые клетки крови с зернистостью в цитоплазме. Три вида, три функции, три причины для внимания.
Нейтрофилы
Главные защитники от бактерий. Норма: 47-72% лейкоцитов. Повышены — инфекция, стресс. Понижены — вирусы, лекарства. Хронический стресс способен менять лейкоцитарную формулу — подробнее об этом на открытом уроке о влиянии длительного стресса.
Эозинофилы
Борцы с паразитами и аллергенами. Норма: 1-5%. Повышены — аллергия, паразиты, аутоиммунные болезни.
Базофилы
Участвуют в аллергических реакциях и воспалении. Норма: 0-1%. Повышение редко, но значимо.
Когда волноваться
Резкое снижение нейтрофилов (ниже 1.0×10⁹/л) — нейтропения, риск инфекций. Резкое повышение — активная инфекция или воспаление. Чтобы научиться видеть за цифрами целостную картину здоровья, начните с вводного семинара по психосоматике.